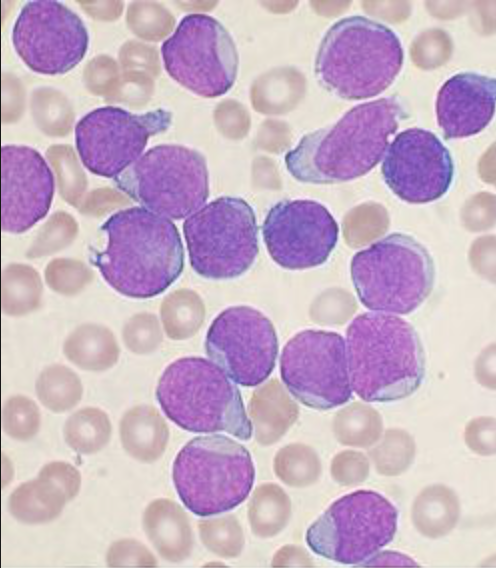

Aberrant
Avviker från det normala. Med “aberrant immunfenotyp” menas att cellerna uttrycker markörer som skiljer sig från det normala uttrycket.
Abscess
Ansamling av pus, varböld.

Adaptation
Reversibel anpassning, kan vara fysiologisk eller patologisk.
Adenocarcinom
En malign tumör som utgår ifrån körtelvävnad.

Agenesi
Avsaknad av anlag.
Akantolys
Förlust av förbindelsen mellan keratinocyter pga förlorad desmosom-funktion.

Akantos
Förtjockning av epidermis alla cellförande lager: stratum basalae, stratum spinosum och stratum granulosum.

Akut leukemi
Malign tumör utgående från omogna celler (blastceller) i de olika poeserna i benmärgen, och spridning till blod, med blastceller i blod (>20%) och/eller benmärg (>20%).
Bilden: Akut lymfatisk leukemi.
Amyloid
Aggregat av proteiner med felaktig veckning.
Bild: Lunga med amyloid.

Amyloidos
Sjukdomar som orsakas av inlagring av amyloid.

Anaplasi
Utebliven differentiering.

Anemi
De röda blodkropparna är för få, för små och/eller innehåller för lite hemoglobin. Hb-värdet är sänkt från patientens normala nivå (Hb <120 g/L för kvinnor, <130 för män).

Aneurysm
Utvidgning av kärl (oftast artärer) eller kavitära organ (tex. atrial septal aneurysm).

Angiogenes
Kärlnybildning, kan vara fysiologisk (sårläkning, utveckling) eller patologisk (neoplasier).

Aplasi
Avsaknad av vävnad, ex. aplastisk anemi som innebär avsaknad av blodbildande märg.
Bild: Aplasia cutis congenita.

Apoptos
Programmerad celldöd, kan vara fysiologisk eller patologisk.

Arterioskleros
Förhärdning av artärer genom hyalininlagring (arterioskleros), skleros av media (Mockenberg) eller ateromatösa plack (ateroskleros).

Ateromatos plack/aterom
Ansamling av fett, inflammatoriska celler och fibros under intima vid ateroskleros.

Atrofi
Tillbakagång, förtvining, minskning av cellers storlek.

Atypi
Morfologi på cellnivå som avviker från det normala, kan ses både vid reaktiva och neoplastiska tillstånd.
Autolys
Enzymatisk nedbrytning av celler och vävnad vid frisläpp av enzymer, t.ex. efter celldöd eller vid bakteriedödning.

Basofil
Färgas blått i eosin-hematoxylin färgning.

Basofili
Ökat antal av basofila granulocyter i blodet.
Blastcell
Den morfologiska beskrivningen av en “omogen cell”, dvs en ej differentierad cell.